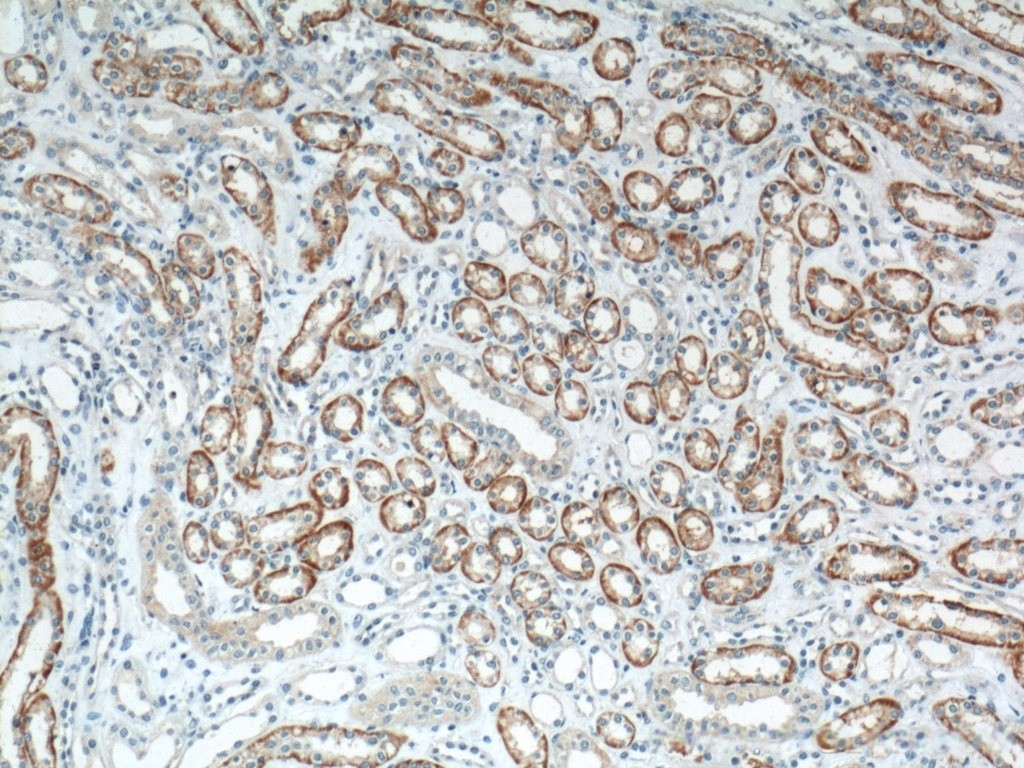
3_副本

| 经过测试的应用 | |
| WB | WB-1:500-1:1000 |
| IHC/IF/IP/COIP | IHC-1:50-1:500 |
| 反应物种 | human, mouse, rat |
| SwissProt ID | Q9H2S6 |
| 抗体类型 | Polyclonal |
| 偶联类型 | Unconjugated |
| 宿主 | Rabbit / IgG |
| 基因名 | TXNIP |
| 分子量 | 44kDa |
| 形式 | Liquid |
| 存储缓冲液 | PBS with 0.02% sodium azide and 50% glycerol, pH 7.3. |
| 储存 | Store at 4°C short term. Aliquot and store at -20°C long term. Avoid freeze/thaw cycles. |

WB result of TXNIP antibody (1:600; incubated at room temperature for 1.5 hours) with sh-Control and sh-TXNIP transfected K-562 cells.

Various lysates were subjected to SDS PAGE followed by western blot with (TXNIP antibody) at dilution of 1:800 incubated at room temperature for 1.5 hours.
Immunohistochemical analysis of paraffin-embedded human kidney tissue slide using (TXNIP Antibody) at dilution of 1:200 (under 10x lens).

Immunohistochemical analysis of paraffin-embedded human ovary tumor tissue slide using (TXNIP antibody) at dilution of 1:200 (under 10x lens)

Immunohistochemical analysis of paraffin-embedded human ovary tumor tissue slide using (TXNIP antibody) at dilution of 1:200 (under 40x lens)

Immunohistochemical analysis of paraffin-embedded mouse colon tissue slide using (TXNIP antibody) at dilution of 1:200 (under 10x lens).

Immunohistochemical analysis of paraffin-embedded rat kidney tissue slide using (TXNIP antibody) at dilution of 1:200 (under 10x lens).

Immunohistochemical analysis of paraffin-embedded human kidney tissue slide using (TXNIP Antibody) at dilution of 1:200 (under 40x lens).
×